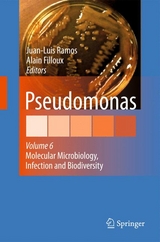
Pseudomonas -

Pseudomonas (eBook)
287 Seiten
Springer Netherland (Verlag)
978-90-481-3909-5 (ISBN)
Paris is a cosmopolitan city where roaring life, wonderful museums and excellent science can be found. It was during the XI IUMS conference held in this city that the Pseudomonas book series was ?rst envisaged. On the ?rst row of the auditorium sat a group of outstanding scientists in the ?eld, who after devoting much of their valuable time, contributed in an exceptional manner to the ?rst three volumes of the series, which saw the light simultaneously. The volumes were grouped under the generic titles of "e;Vol. I. Pseudomonas: Genomics, Life Style and Molecular Architecture"e;, Vol. II. Pseudomonas: Virulence and gene regulation; Vol. III. Pseudomonas: Biosynthesis of Macromolecules and Molecular Metabolism. Soon after the completion of the ?rst three volumes, a rapid search for ar- cles containing the word Pseudomonas in the title in the last 10 years produced over 6,000 articles! Consequently, not all possible topics relevant to this genus were covered in the three ?rst volumes. Since then two other volumes were p- lished: Pseudomonas volume IV edited by Roger Levesque and Juan L. Ramos that came to being with the intention of collecting some of the most relevant emerging new issues that had not been dealt with in the three previous volumes. This v- ume was arranged after the Pseudomonas meeting organized by Roger Levesque in Quebec (Canada). It dealt with various topics grouped under a common heading: "e;Pseudomonas: Molecular Biology of Emerging Issues"e;.
Preface 6
Contents 8
Contributors 10
Obituary 12
Part I Regulation and Control of Virulence 14
1 Small RNAs of Pseudomonas spp. 16
1.1 Introduction 16
1.2 Overview of Observed sRNAs in P. aeruginosa 18
1.3 Examples of sRNAs in Pseudomonas spp. 23
1.3.1 6S RNA 23
1.3.2 4.5S RNA 25
1.3.3 tmRNA 27
1.3.4 RNase P RNA 28
1.3.5 Processed Leader Transcripts 28
1.3.6 sRNAs Sequestering Proteins of the RsmA Family 29
1.3.7 RgsA sRNA Involved in Oxidative Stress Response 33
1.3.8 Fur-Regulated PrrF sRNAs 33
1.3.9 PhrS sRNA, an Anaerobic Regulator of PQS Synthesis 35
1.4 Concluding Remarks 35
References 36
2 2-Alkyl-4(1 H )-Quinolone Signalling in Pseudomonas aeruginosa 42
2.1 Introduction to 2-Alkyl-4(1 H )-quinolone Quorum Sensing in Pseudomonas aeruginosa 42
2.2 Nomenclature and Abbreviations 45
2.3 AQ Spectrum Produced by P. aeruginosa 46
2.4 Properties of AQs 48
2.5 Biosynthesis of AQs 48
2.6 Regulation of AQ Production 52
2.6.1 AQs and the las / rhl QS Systems of P. aeruginosa 52
2.7 Autoregulation of AQs 54
2.8 Other Regulators of AQs 56
2.9 Effects of AQs on Expression and Production of Virulence Factors 56
2.10 AQs and Iron 58
2.11 The Role of AQs in Infection 59
2.12 AQs in Other Bacteria 62
2.13 Concluding Remarks 62
References 64
3 Cell-Surface Signalling in Pseudomonas 72
3.1 Introduction 72
3.2 Structure of the Cell-Surface Signalling System 74
3.2.1 TonB and the TonB-Dependent Transducer 75
3.2.2 ECF Sigma Factor Regulator 79
3.2.3 ECF Sigma Factor 80
3.3 P. aeruginosa Cell-Surface Signalling Systems 81
3.3.1 Pyoverdine-Mediated Signalling Pathway 83
3.3.2 Ferric Citrate-Mediated Signalling Pathway 86
3.3.3 Iron-Siderophore-Mediated Signalling Pathways 87
3.3.4 Haem-Mediated Signalling Pathway 88
3.3.5 Other CSS Pathways Involved in the Regulation of Metal Uptake 89
3.3.6 Regulation of Pyocins by a CSS System 90
3.3.7 Regulation of Virulence by a CSS System 90
3.4 Cell-Surface Signalling Systems in Other pseudomonas 91
3.4.1 P. putida 92
3.4.2 P. fluorescens 102
3.4.3 P. syringae and P. entomophila 102
3.5 Concluding Remarks 103
References 104
4 Second Messenger c-di-GMP Signaling in Pseudomonas aeruginosa 110
4.1 Introduction 110
4.2 Purine Nucleotides as Second Messengers 111
4.2.1 Stringent Response and (p)ppGpp. 111
4.2.2 cAMP and cGMP Signaling 111
4.3 Discovery of c-di-GMP in Bacteria 113
4.4 Distribution of Genes Encoding Enzymes for c-di-GMP Metabolism in Pseudomonas aeruginosa 114
4.5 Structure-Function Relationships of c-di-GMP Diguanylate Cyclases and Phosphodiesterases 119
4.6 Models for c-di-GMP Signaling: Specificity of c-di-GMP Activity and the Redundancy of Phosphodiesterases and Diguanylate Cyclases 119
4.7 Diguanylate Cyclases and Phosphodiesterases of P. aeruginosa 122
4.7.1 The WspR and the Chemotransducing System Controlling Surface Properties of P. aeruginosa 123
4.7.2 SadC and BifA: Other DGCs and PDEs Involved in Biofilm Formation 127
4.7.3 MucR and Alginate Regulation 128
4.7.4 MorA, PA1120 and the Regulation of the CupA Fimbrial System 131
4.7.5 PvrR 131
4.7.6 Arr and Regulation of Antibiotic Induced Bifilm Formation 132
4.7.7 FimX and the Function of Type IV Pili 133
4.7.8 RocR/SadR and Transcriptional Regulation of Expression of CupB, CupC and the Type III Secretion System 133
4.7.9 ToxR/RegA and Regulation of Expression of Exotoxin A 135
4.8 C-di-GMP Receptors 135
4.8.1 Allosteric Inhibitory I-Sites in the GGDEF Domain 136
4.8.2 The c-di-GMP Catalytic Site of EAL and HD-GYP Domains 137
4.8.3 PilZ Domains and the Role of Alg44 in Alginate Biosynthesis 138
4.8.4 PelD and Allosteric Control of Pel Polysaccharide Production 141
4.8.5 FleQ and the Control of Transcription of Pel Polysaccharide Biosynthetic Genes 142
4.9 Concluding Remarks 142
References 144
Part II Life Styles 152
5 Emergence of Pseudomonas aeruginosa in Cystic Fibrosis Lung Infections 154
5.1 Introduction 154
5.2 Cystic Fibrosis 154
5.2.1 CFTR Gene 155
5.2.2 CFTR Mutations 155
5.2.3 CFTR Modifiers 155
5.2.4 Role of CFTR in Cellular Functions 156
5.3 Epidemiology of Infections in CF 157
5.3.1 Viral Infections 157
5.3.2 Bacterial Infections 159
5.3.3 Fungal Infections 162
5.3.4 Newer Non-Culture Detection Methods 162
5.4 Infection Models of CF 163
5.4.1 Tissue Culture Models 163
5.4.2 Animal Models 164
5.4.3 CF Pig 164
5.5 Phenotypes of P. aeruginosa Isolates from CF Infections 164
5.5.1 Mucoidy and Alginate Production 165
5.5.2 Biofilm Formation 167
5.5.3 Type III Secretion 168
5.5.4 Genetic Regulation 169
5.5.5 Motility 169
5.5.6 Lipopolysaccharide (LPS) 170
5.5.7 Phosphorylcholine (ChoP) 171
5.5.8 Response to Growth in the CF Lung 171
5.6 Genomic Analyses of P. aeruginosa Strains 172
5.7 Therapeutic Options 175
5.7.1 Targeting Essential Genes 175
5.7.2 Vaccines 175
5.7.3 Biofilm Inhibition 177
5.7.4 Targeting Defective CFTR Function 177
5.8 Conclusions 178
References 178
6 Insights into the Life Styles of Pseudomonas stutzeri 190
6.1 Introduction 190
6.2 Phylogeny and Genomovars 191
6.3 Core/Pan Genome 195
6.4 Role of Mobile Genetic Elements 199
6.5 Adaptation to Ecological Niches Ecotypes
6.5.1 Soil and Plant-Associated 200
6.5.2 Groundwater 202
6.5.3 Marine Environment 203
6.5.4 Clinical Samples 205
6.5.5 Genomovar, Habitat, and Niche-Adaptation 206
6.6 Speciation: Gain and Loss of Genes Future Outlook 207
References 208
Part III Physiology, Metabolism and Markers 212
7 Pyoverdine Siderophores as Taxonomic and Phylogenic Markers 214
7.1 Introduction 214
7.2 Taxonomic Diversity Among Pseudomonas 215
7.3 Pyoverdine Diversity Among Fluorescent Pseudomonas 219
7.3.1 The Pyoverdine Molecule 219
7.3.2 Isoelectrophoresis as a Powerful Siderotyping Method 222
7.3.3 Pyoverdine-Mediated Iron Uptake as a Complementary Powerful Siderotyping Method 223
7.4 Siderotyping of the Fluoresc ent Pseudomonas Sp ecies 223
7.4.1 Fluorescent Pseudomonas Species Analyzed Through Siderotyping 224
7.4.2 Analysis of the Fluorescent Pseudomonas Species Through Siderotyping 225
7.4.2.1 Analysis of the Fluorescent Pseudomonas Species Through Isoelectrophoresis 225
7.4.2.2 Analysis of the Fluorescent Pseudomonas Species Through Iron Uptake 230
7.4.2.3 Conclusive Remarks on Siderotyping 231
7.4.3 Pyoverdines as Taxonomic Markers: Correlations Between Pyoverdines and Fluorescent Pseudomonas Species 234
7.4.4 Pyoverdines, as Phylogenic Markers 236
7.5 Conclusions 238
References 239
8 Metabolism of Acyclic Terpenes by Pseudomonas 248
8.1 Introduction 248
8.2 Terpenes/Isoprenoids Sources 249
8.2.1 Terpenes/Isoprenoids as Plant Components 249
8.2.2 Terpenes/Isoprenoids as Petroleum Components 251
8.2.3 Terpenes/Isoprenoids as Bacterial Components 251
8.3 Branched-Chain Alkane Degradation 251
8.3.1 2-Methyl Branched-Chain Alkanes Degradation 252
8.3.2 3-Methyl Branched-Chain Alkanes Degradation 252
8.4 Acyclic Terpenes Metabolism in Pseudomonas 253
8.4.1 Introduction to Acyclic Terpenes Catabolism 253
8.4.2 Acyclic Terpenes Catabolic Pathway 254
8.4.2.1 Upper Oxidation-Activation Pathway 254
8.4.2.2 Central ATU Pathway 254
8.4.2.3 -Oxidation Coupling to the ATU Pathway 257
8.4.2.4 LIU-Convengence to ATU Pathway 258
8.4.3 Carboxylases Involved in Acyclic Terpene Catabolism 259
8.4.3.1 Common Properties of GCCase and MCCase Enzymes 259
8.4.3.2 Kinetic Parameters of the GCCase 259
8.4.3.3 Kinetic Parameters of Recombinant MCCase 260
8.5 Regulation of the Atu and Liu Gene Clusters 260
8.6 Atu/liu Homologous Clusters Among Pseudomonas Species 261
8.7 Other Genes Involved in Acyclic Terpenes Catabolism 263
8.8 Conclusion Remarks 263
References 264
9 Heavy Metal Resistance in Pseudomonads 268
9.1 Introduction 268
9.2 Micronutrient Cations 269
9.2.1 Copper 269
9.2.2 Cobalt and Nickel 271
9.2.3 Zinc 273
9.3 Toxic Cations 274
9.3.1 Cadmium and Lead 274
9.3.2 Mercury 277
9.4 Toxic Oxyanions 279
9.4.1 Arsenic 279
9.4.2 Chromium 282
9.4.3 Tellurium 285
9.5 Other Toxic Ions 286
9.6 Concluding Remarks 287
References 287
Index 296
| Erscheint lt. Verlag | 10.3.2010 |
|---|---|
| Zusatzinfo | XII, 287 p. |
| Verlagsort | Dordrecht |
| Sprache | englisch |
| Themenwelt | Medizin / Pharmazie ► Medizinische Fachgebiete ► Mikrobiologie / Infektologie / Reisemedizin |
| Studium ► 1. Studienabschnitt (Vorklinik) ► Biochemie / Molekularbiologie | |
| Studium ► 2. Studienabschnitt (Klinik) ► Humangenetik | |
| Naturwissenschaften ► Biologie ► Genetik / Molekularbiologie | |
| Naturwissenschaften ► Biologie ► Mikrobiologie / Immunologie | |
| Technik | |
| Schlagworte | Bacteria • Bacteriology • gene expression • Genetics • Microbiology • Molecular Biology • quorum sensing |
| ISBN-10 | 90-481-3909-0 / 9048139090 |
| ISBN-13 | 978-90-481-3909-5 / 9789048139095 |
| Informationen gemäß Produktsicherheitsverordnung (GPSR) | |
| Haben Sie eine Frage zum Produkt? |
Größe: 5,3 MB
DRM: Digitales Wasserzeichen
Dieses eBook enthält ein digitales Wasserzeichen und ist damit für Sie personalisiert. Bei einer missbräuchlichen Weitergabe des eBooks an Dritte ist eine Rückverfolgung an die Quelle möglich.
Dateiformat: PDF (Portable Document Format)
Mit einem festen Seitenlayout eignet sich die PDF besonders für Fachbücher mit Spalten, Tabellen und Abbildungen. Eine PDF kann auf fast allen Geräten angezeigt werden, ist aber für kleine Displays (Smartphone, eReader) nur eingeschränkt geeignet.
Systemvoraussetzungen:
PC/Mac: Mit einem PC oder Mac können Sie dieses eBook lesen. Sie benötigen dafür einen PDF-Viewer - z.B. den Adobe Reader oder Adobe Digital Editions.
eReader: Dieses eBook kann mit (fast) allen eBook-Readern gelesen werden. Mit dem amazon-Kindle ist es aber nicht kompatibel.
Smartphone/Tablet: Egal ob Apple oder Android, dieses eBook können Sie lesen. Sie benötigen dafür einen PDF-Viewer - z.B. die kostenlose Adobe Digital Editions-App.
Zusätzliches Feature: Online Lesen
Dieses eBook können Sie zusätzlich zum Download auch online im Webbrowser lesen.
Buying eBooks from abroad
For tax law reasons we can sell eBooks just within Germany and Switzerland. Regrettably we cannot fulfill eBook-orders from other countries.
aus dem Bereich